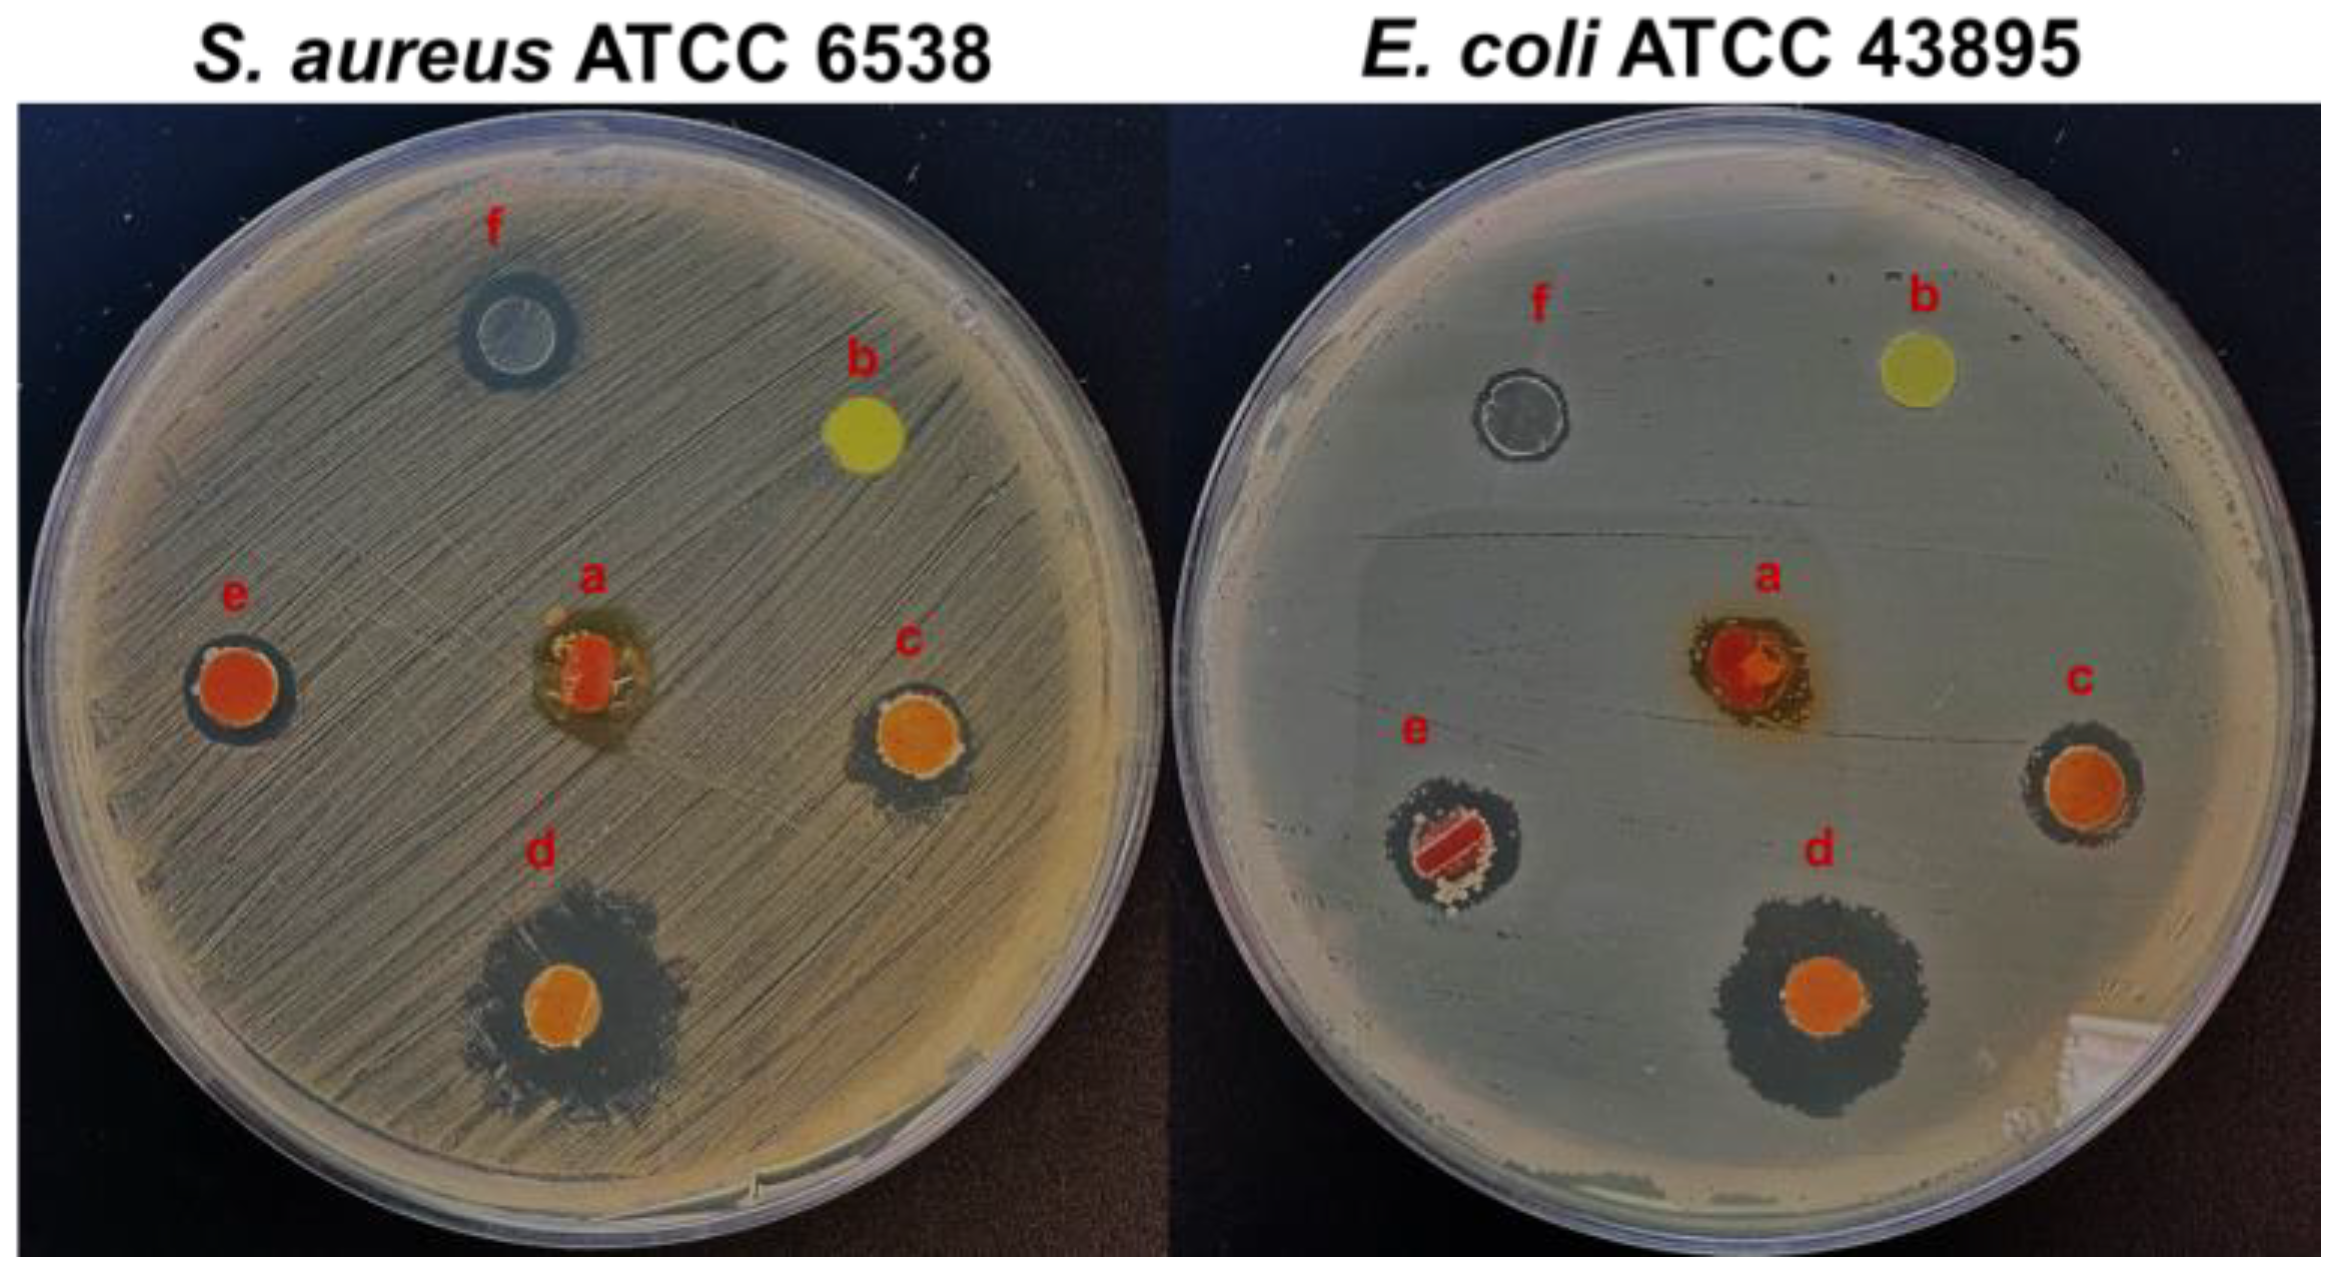
Polymers 15 01021 g006 Polymers 15 01021 g006

Sustainable Chitosan/Polybenzoxazine Films: Synergistically Improved Thermal, Mechanical, and Antimicrobial Properties
Abstract
1. Introduction
2. Materials and Methods
2.1. Chemicals and Materials
2.2. Synthesis of Curcumin-Furfuryl Amine Based Benzoxazine Monomer (C-fu)
2.3. Synthesis of Ch/C-fu Blends
2.4. Instrumentation Methods
2.5. In Vitro Antibacterial Activity and MIC Determination
2.6. Antibiofilm Potency of Ch/Poly (C-fu) (40/60) against E. coli and S. aureus
2.7. Biofilm Observations by Confocal Laser Scanning Microscopy
3. Results and Discussion
3.1. Structural Confirmation of the Synthesized Benzoxazine Monomer (C-fu)
3.2. Polymerization Behavior of Poly(Ch/C-fu) Blends
3.3. Tensile Properties of Poly(Ch/C-fu) Films
3.4. Thermal Stabilities of Poly(Ch/C-fu) Films
3.5. Flame Retardant Properties of Poly(Ch/C-st) Films
3.6. Determination of the Antibacterial Efficacy of Poly(Ch/C-fu) Films
3.7. Antibiofilm Potencies of Ch/poly(C-fu) (40/60) against E. coli and S. aureus
4. Conclusions
Author Contributions
Funding
Institutional Review Board Statement
Informed Consent Statement
Data Availability Statement
Conflicts of Interest
References
- Bhattacharya, M.; Reis, R.L.; Correlo, V.; Boesel, L. Biodegradable Polymers for Industrial Applications; Smith, R., Ed.; CRC Press: Boca Raton, FL, USA, 2005; pp. 336–455. [Google Scholar]
- Jin, O.; Schexnailder, P.; Gaharwar, A.K.; Schmidt, G. Silicate cross-linked bio-nanocomposite hydrogels from PEO and chitosan. Macromol. Biosci. 2009, 9, 1028–1035. [Google Scholar] [CrossRef] [PubMed]
- Chuck, B.T.; Karen, J.L. Absorbable and Biodegradable Polymers; Shalaby, S.W., Burg, K.J.L., Eds.; Advances in Polymeric Biomaterials Series; CRC Press: Boca Raton, FL, USA, 2004; pp. 159–171. [Google Scholar]
- Van der Zee, M. Handbook of Biodegradable Polymers; Bastioli, C., Ed.; Rapra Technology Limited: Shawbury, UK, 2005; pp. 1–31. [Google Scholar]
- Boey, J.Y.; Mohamad, L.; Khok, Y.S.; Tay, G.S.; Baidurah, S. A Review of the applications and biodegradation of polyhydroxyalkanoates and poly(lactic acid) and its composites. Polymers 2021, 13, 1544. [Google Scholar] [CrossRef]
- Roussy, J.; Chastellan, P.; Vooren, M.; Guibal, E. Treatment of ink-containing wastewater by coagulation/flocculation using biopolymers. Water SA 2005, 3, 369–376. [Google Scholar] [CrossRef]
- Jin, J.; Song, M.; Hourston, D.J. Novel chitosan-based films cross-linked by genipin with improved physical properties. Biomacromolecules 2004, 5, 162–168. [Google Scholar] [CrossRef]
- Singh, A.; Narvi, S.S.; Dutta, P.K.; Pandey, N.D. External stimuli response on a novel chitosan hydrogel crosslinked with formaldehyde. Bull. Mater. Sci. 2006, 29, 233–238. [Google Scholar] [CrossRef]
- Grande, R.; Caryalho, A.J.F. Compatible ternary blends of chitosan/poly(vinyl alcohol)/poly(lactic acid) produced by oil-in-water emulsion processing. Biomacromolecules 2011, 12, 907–914. [Google Scholar] [CrossRef] [PubMed]
- Singh, J.; Dutta, P.K.; Dutta, J.; Hunt, A.J.; Macquarrie, D.J.; Clark, J.H. Preparation and properties of highly soluble chitosan–l-glutamic acid aerogel derivative. Carbohydr. Polym. 2009, 76, 188–195. [Google Scholar] [CrossRef]
- Tiwari, A.; Singh, V. Synthesis and characterization of electrical conducting chitosan-graft-polyaniline. Express Polym. Lett. 2007, 1, 308–317. [Google Scholar] [CrossRef]
- Mahdavinia, G.R.; Pourjavadi, A.; Hosseinzadeh, H.; Zohuriaan, M. Modified chitosan 4. Superabsorbent hydrogels from poly(acrylic acid-co-acrylamide) grafted chitosan with salt- and pH-responsiveness properties. Eur. Polym. J. 2004, 40, 1399–1407. [Google Scholar] [CrossRef]
- Shchipunov, Y.; Ivanova, N.; Silantev, V. Bionanocomposites formed by in situ charged chitosan with clay. Green Chem. 2009, 11, 1758–1761. [Google Scholar] [CrossRef]
- Park, J.; Lee, H.W.; Chae, D.K. Electrospinning and characterization of poly(vinyl alcohol)/chitosan oligosaccharide/clay nanocomposite nanofibers in aqueous solutions. Colloid Polym. Sci. 2009, 287, 943–950. [Google Scholar] [CrossRef]
- Bhatnagar, A.; Sillanpaa, M. Applications of chitin- and chitosan-derivatives for the detoxification of water and wastewater--a short review. Adv. Colloid Interface Sci. 2009, 152, 26–38. [Google Scholar] [CrossRef]
- Miretzky, P.; Cirelli, A.F. Hg(II) removal from water by chitosan and chitosan derivatives: A review. J. Hazard. Mater. 2009, 167, 10–23. [Google Scholar] [CrossRef] [PubMed]
- Du, J.; Hsieh, Y.L. Cellulose/chitosan hybrid nanofibers from electrospinning of their ester derivatives. Cellulose 2009, 16, 247–260. [Google Scholar] [CrossRef]
- Marcasuzaa, P.; Reynaud, S.; Ehrenfeld, F.; Khouhk, A.D. Chitosan-graft-polyaniline-based hydrogels: Elaboration and properties. Biomacromolecules 2010, 11, 1684–1691. [Google Scholar] [CrossRef] [PubMed]
- Dufresne, A.; Cavaille, J.; Dupeyre, D.; Garcia-Ramirez, M.R. Chain flow in thermo-stimulated creep experiments: Application to poly(methyl methacrylate). Polymer 1999, 40, 1657–1666. [Google Scholar] [CrossRef]
- Koyano, T.; Koshizaki, N.; Umehara, H.; Nagura, M.; Minoura, N. Surface states of PVA/chitosan blended hydrogels. Polymer 2000, 41, 4461–4465. [Google Scholar] [CrossRef]
- Twu, Y.K.; Huang, H.I.; Chang, S.Y.; Wang, S.L. Preparation and sorption activity of chitosan/cellulose blend beads. Carbohydr. Polym. 2003, 54, 425–430. [Google Scholar] [CrossRef]
- Al-Larawi, A.J.M.; Al-Qaisi, Z.H.J.; Abdullah, H.I.; Al-Mokaram, A.M.A.; Al-Heetimi, D.T.A. Synthesis, characterization of acrylamide grafted chitosan and its use in removal of copper(II) ions from water. Carbohydr. Polym. 2011, 83, 495–500. [Google Scholar] [CrossRef]
- Baran, E.T.; Mano, J.F.; Reis, R.L. Starch–chitosan hydrogels prepared by reductive alkylation cross-linking. J. Mater. Sci. Mater. Med. 2004, 15, 759–765. [Google Scholar] [CrossRef]
- Wang, H.; Li, W.; Lu, Y.; Wang, Z. Studies on chitosan and poly(acrylic acid) interpolymer complex. I. Preparation, structure, pH-sensitivity, and salt sensitivity of complex-forming poly(acrylic acid): Chitosan semi-interpenetrating polymer network. J. Appl. Polym. Sci. 1997, 65, 1445–1450. [Google Scholar] [CrossRef]
- Liang, S.; Liu, L.; Huang, Q.; Yam, K. Preparation of single or double-network chitosan/poly(vinyl alcohol) gel films through selectively cross-linking method. Carbohydr. Polym. 2009, 77, 718–724. [Google Scholar] [CrossRef]
- Chang, X.; Chen, D.; Jiao, X. Chitosan-based aerogels with high adsorption performance. J. Phys. Chem. B 2008, 112, 7721–7725. [Google Scholar] [CrossRef]
- Ratto, J.A.; Chen, C.C.; Blumstein, R.B. Phase behavior study of chitosan/polyamide blends. J. Appl. Polym. Sci. 1996, 59, 1451–1461. [Google Scholar] [CrossRef]
- Holly, F.W.; Cope, A.C. Condensation products of aldehydes and ketones with o-aminobenzyl alcohol and o-hydroxybenzylamine. J. Am. Chem. Soc. 1944, 66, 1875–1879. [Google Scholar] [CrossRef]
- Ishida, H. Handbook of Benzoxazine Resins; Ishida, H., Agag, T., Eds.; Elsevier: Amsterdam, The Netherlands, 2011; pp. 3–81. [Google Scholar]
- Sawaryn, C.; Landfester, K.; Taden, A. Cationic Polybenzoxazines. A novel polyelectrolyte class with adjustable solubility and unique hydrogen-bonding capabilities. Macromolecules 2011, 44, 7668–7674. [Google Scholar] [CrossRef]
- Takeichi, T.; Agag, T. High Performance Polybenzoxazines as Novel Thermosets. High Perform. Polym. 2006, 18, 777–797. [Google Scholar] [CrossRef]
- Yagci, Y.; Kiskan, B.; Ghosh, N.N. Recent advancement on polybenzoxazine—A newly developed high performance thermoset. J. Polym. Sci. Part A Polym. Chem. 2009, 47, 5565–5576. [Google Scholar] [CrossRef]
- Heinze, T.; Siebert, M.; Berlin, P.; Koschella, A. Biofunctional materials based on amino cellulose derivatives-a nanobiotechnological concept. Macromol. Biosci. 2016, 16, 10–42. [Google Scholar] [CrossRef]
- Thirukumaran, P.; Shakila Parveen, A.; Sarojadevi, M. Replacing bisphenol-A with bisguaiacol-F to synthesize polybenzoxazines for a pollution-free environment. New J. Chem. 2015, 39, 1691–1702. [Google Scholar]
- Omura, Y.; Taruno, Y.; Irisa, Y.; Morimoto, M.; Saimoto, H.; Shigemasa, Y. Regioselective mannich reaction of phenolic compounds and its application to the synthesis of new chitosan derivatives. Tetrahedron Lett. 2001, 42, 7273–7275. [Google Scholar] [CrossRef]
- Thirukumaran, P.; Shakila Parveen, A.; Atchudan, R.; Kim, S.-C. Sustainability and antimicrobial assessments of bio based polybenzoxazine film. Eur. Polym. J. 2018, 109, 248–256. [Google Scholar] [CrossRef]
- Bauer, A.W.; Kirby, W.M.; Sherris, J.C.; Turck, M. Antibiotic susceptibility testing by a standardized single disk method. Am. J. Clin. Pathol. 1966, 45, 493–496. [Google Scholar] [CrossRef] [PubMed]
- Mohamed, A.A.; Abu-Elghait, M.; Ahmed, N.E.; Salem, S.S. Eco-friendly mycogenic synthesis of ZnO and CuO nanoparticles for in vitro antibacterial, antibiofilm, and antifungal applications. Biol. Trace Elem. Res. 2021, 199, 2788–2799. [Google Scholar] [CrossRef] [PubMed]
- Document M07-A10; Clinical Laboratory Standards Institute Methods for Dilution Antimicrobial Susceptibility Tests for Bacteria That Grow Aerobically Approved Standard. 10th ed. CLSI: Wayne, PA, USA, 2015.
- Kim, Y.G.; Lee, J.-H.; Raorane, C.J.; Oh, S.T.; Park, J.G.; Lee, J. Herring oil and omega fatty acids inhibit staphylococcus aureus biofilm formation and virulence. J. Front. Microbiol. 2018, 9, 1241. [Google Scholar] [CrossRef] [PubMed]
- Raorane, C.J.; Lee, J.-H.; Kim, Y.-G.; Rajasekharan, S.K.; Garcia-Contreras, R.; Lee, J. Antibiofilm and antivirulence efficacies of flavonoids and curcumin against acinetobacter baumannii. J. Front. Microbiol. 2019, 10, 990. [Google Scholar] [CrossRef]
- Runci, F.; Bonchi, C.; Frangipani, E.; Visaggio, D.; Visca, P. Acinetobacter baumannii biofilm formation in human serum and disruption by gallium. Antimicrob. Agents Chemother. 2017, 61, e01563-16. [Google Scholar] [CrossRef]
- Heinze, T.; Liebert, T.; Koschella, A. Esterification of Polysaccharides; Springer: Berlin/Heidelberg, Germany, 2006; pp. 12–14. [Google Scholar]
- Thirukumaran, P.; Shakila Parveen, A.; Sarojadevi, M. Synthesis and copolymerization of fully biobased benzoxazines from renewable resources. ACS Sustain. Chem. Eng. 2014, 2, 2790–2801. [Google Scholar] [CrossRef]
- Heinze, T.; Pfeifer, A.; Koschella, A.; Schaller, J.; Meister, F. Solvent-free synthesis of 6-deoxy-6-(ω-aminoalkyl)amino cellulose. J. Appl. Polym. Sci. 2016, 39, 133. [Google Scholar] [CrossRef]
- Yang, P.; Gu, Y. A novel benzimidazole moiety-containing benzoxazine: Synthesis, polymerization, and thermal properties. J. Polym. Sci. Part A Polym. Chem. 2012, 50, 1261–1271. [Google Scholar] [CrossRef]
- Burke, W.J. 3,4-dihydro-1,3,2H-benzoxazines. Reaction of p-substituted phenols with N,N-dimethylolamines. J. Am. Chem. Soc. 1949, 71, 609–612. [Google Scholar] [CrossRef]
- Thirukumaran, P.; Shakila Parveen, A.; Sarojadevi, M. Synthesis and characterization of novel bio-based benzoxazines from eugenol. RSC Adv. 2014, 4, 7959–7966. [Google Scholar] [CrossRef]
- Baqar, M.; Agag, T.; Ishida, H.; Qutubuddin, S. Poly(benzoxazine- co-urethane)s: A new concept for phenolic/urethane copolymers via one-pot method. Polymer 2011, 52, 307–317. [Google Scholar] [CrossRef]
- Thirukumaran, P.; Ranjith Kumar, M.; Shakila Parveen, A.; Atchudan, R.; Kim, S.-C. Sustainability and antimicrobial assessments of apigenin based polybenzoxazine film. Polymer 2019, 172, 100–109. [Google Scholar] [CrossRef]
- Demir, K.D.; Kiskan, B.; Yagci, Y. Thermally curable acetylene-containing main-chain benzoxazine polymers via sonogashira coupling reaction. Macromolecules 2011, 44, 1801–1807. [Google Scholar] [CrossRef]
- Rajput, A.B.; Ghosh, N.N. Preparation and characterization of novel polybenzoxazine–polyester resin blends. Int. J. Polym. Mater. 2011, 60, 27–39. [Google Scholar] [CrossRef]
- Li, X.; Xia, Y.; Xu, W.; Ran, Q.; Gu, Y. The curing procedure for a benzoxazine–cyanate–epoxy system and the properties of the terpolymer. Polym. Chem. 2012, 3, 1629–1633. [Google Scholar] [CrossRef]
- van Krevelen, D.W. Some basic aspects of flame resistance of polymeric materials. Polymer 1975, 16, 615–620. [Google Scholar] [CrossRef]
- Li, C.; Kang, N.J.; Labrandero, S.D.; Wan, J.; Lez, C.G.; Wang, D.Y. Synergistic effect of carbon nanotube and polyethersulfone on flame retardancy of carbon fiber reinforced epoxy composites. Ind. Eng. Chem. Res. 2014, 53, 1040–1047. [Google Scholar] [CrossRef]
- Thirukumaran, P.; Chaitany, J.R.; Rajesh, H.; Shakila Parveen, A.; Kim, S.-C. Development of arbutin based sustainable polybenzoxazine resin for antifouling and anticorrosion of low carbon steel. Prog. Org. Coat. 2022, 170, 106968. [Google Scholar]
- Kong, M.; Chen, X.G.; Xing, K.; Park, H.J. Antimicrobial properties of chitosan and mode of action: A state of the art review. Int. J. Food Microbiol. 2010, 144, 51–63. [Google Scholar] [CrossRef]
- Divya, K.; Vijayan, S.; George, T.K.; Jisha, M.S. Antimicrobial properties of chitosan nanoparticles: Mode of action and factors affecting activity. Fibers Polym. 2017, 18, 221–230. [Google Scholar] [CrossRef]
- Khan, A.M.; Abid, O.R.; Mir, S. Assessment of biological activities of chitosan Schiff base tagged with medicinal plants. Biopolymers 2019, 111, e23338. [Google Scholar] [CrossRef] [PubMed]
- Hawver, L.A.; Jung, S.A.; Ng, W.L. Specificity and complexity in bacterial quorum-sensing systems. FEMS Microbiol. Rev. 2016, 40, 738–752. [Google Scholar] [CrossRef] [PubMed]

| Sample | TOnset (°C) | TMax (°C) | Tfinal (°C) | ∆H (J/g) |
|---|---|---|---|---|
| Poly(Ch/C-fu) (0/100) | 151 | 210 | 243 | 197 |
| Poly(Ch/C-fu) (20/80) | 144 | 204 | 237 | 152 |
| Poly(Ch/C-fu) (40/60) | 136 | 193 | 228 | 108 |
| Poly(Ch/C-fu) (60/40) | 130 | 190 | 223 | 63 |
| Poly(Ch/C-fu) (80/20) | 127 | 186 | 216 | 38 |
| Poly(Ch/C-fu) (0/100) | - | - | - | - |
| Bacterial Strains | Inhibition Zone (mm) | |||||
|---|---|---|---|---|---|---|
| CC 0/100 | CC 20/80 | CC 40/60 | CC 60/40 | CC 80/20 | CC 100/0 | |
| S. aureus ATCC 6538 | 11 ± 1.1 | 9 ± 1.3 | 18.5 ± 0.9 | 9.5 ± 0.5 | 7 ± 0.5 | 11.5 ± 0.9 |
| E. coli ATCC 43895 | 8 ± 2.3 | 10.5 ± 0.8 | 18 ± 0.5 | 10.5 ± 0.8 | 7 ± 0.7 | 12.7 ± 1.1 |
Disclaimer/Publisher’s Note: The statements, opinions and data contained in all publications are solely those of the individual author(s) and contributor(s) and not of MDPI and/or the editor(s). MDPI and/or the editor(s) disclaim responsibility for any injury to people or property resulting from any ideas, methods, instructions or products referred to in the content. |
© 2023 by the authors. Licensee MDPI, Basel, Switzerland. This article is an open access article distributed under the terms and conditions of the Creative Commons Attribution (CC BY) license (https://creativecommons.org/licenses/by/4.0/).
Share and Cite
Periyasamy, T.; Asrafali, S.P.; Raorane, C.J.; Raj, V.; Shastri, D.; Kim, S.-C. Sustainable Chitosan/Polybenzoxazine Films: Synergistically Improved Thermal, Mechanical, and Antimicrobial Properties. Polymers 2023, 15, 1021. https://doi.org/10.3390/polym15041021
Periyasamy T, Asrafali SP, Raorane CJ, Raj V, Shastri D, Kim S-C. Sustainable Chitosan/Polybenzoxazine Films: Synergistically Improved Thermal, Mechanical, and Antimicrobial Properties. Polymers. 2023; 15(4):1021. https://doi.org/10.3390/polym15041021
Chicago/Turabian StylePeriyasamy, Thirukumaran, Shakila Parveen Asrafali, Chaitany Jayprakash Raorane, Vinit Raj, Divya Shastri, and Seong-Cheol Kim. 2023. "Sustainable Chitosan/Polybenzoxazine Films: Synergistically Improved Thermal, Mechanical, and Antimicrobial Properties" Polymers 15, no. 4: 1021. https://doi.org/10.3390/polym15041021
APA StylePeriyasamy, T., Asrafali, S. P., Raorane, C. J., Raj, V., Shastri, D., & Kim, S.-C. (2023). Sustainable Chitosan/Polybenzoxazine Films: Synergistically Improved Thermal, Mechanical, and Antimicrobial Properties. Polymers, 15(4), 1021. https://doi.org/10.3390/polym15041021

